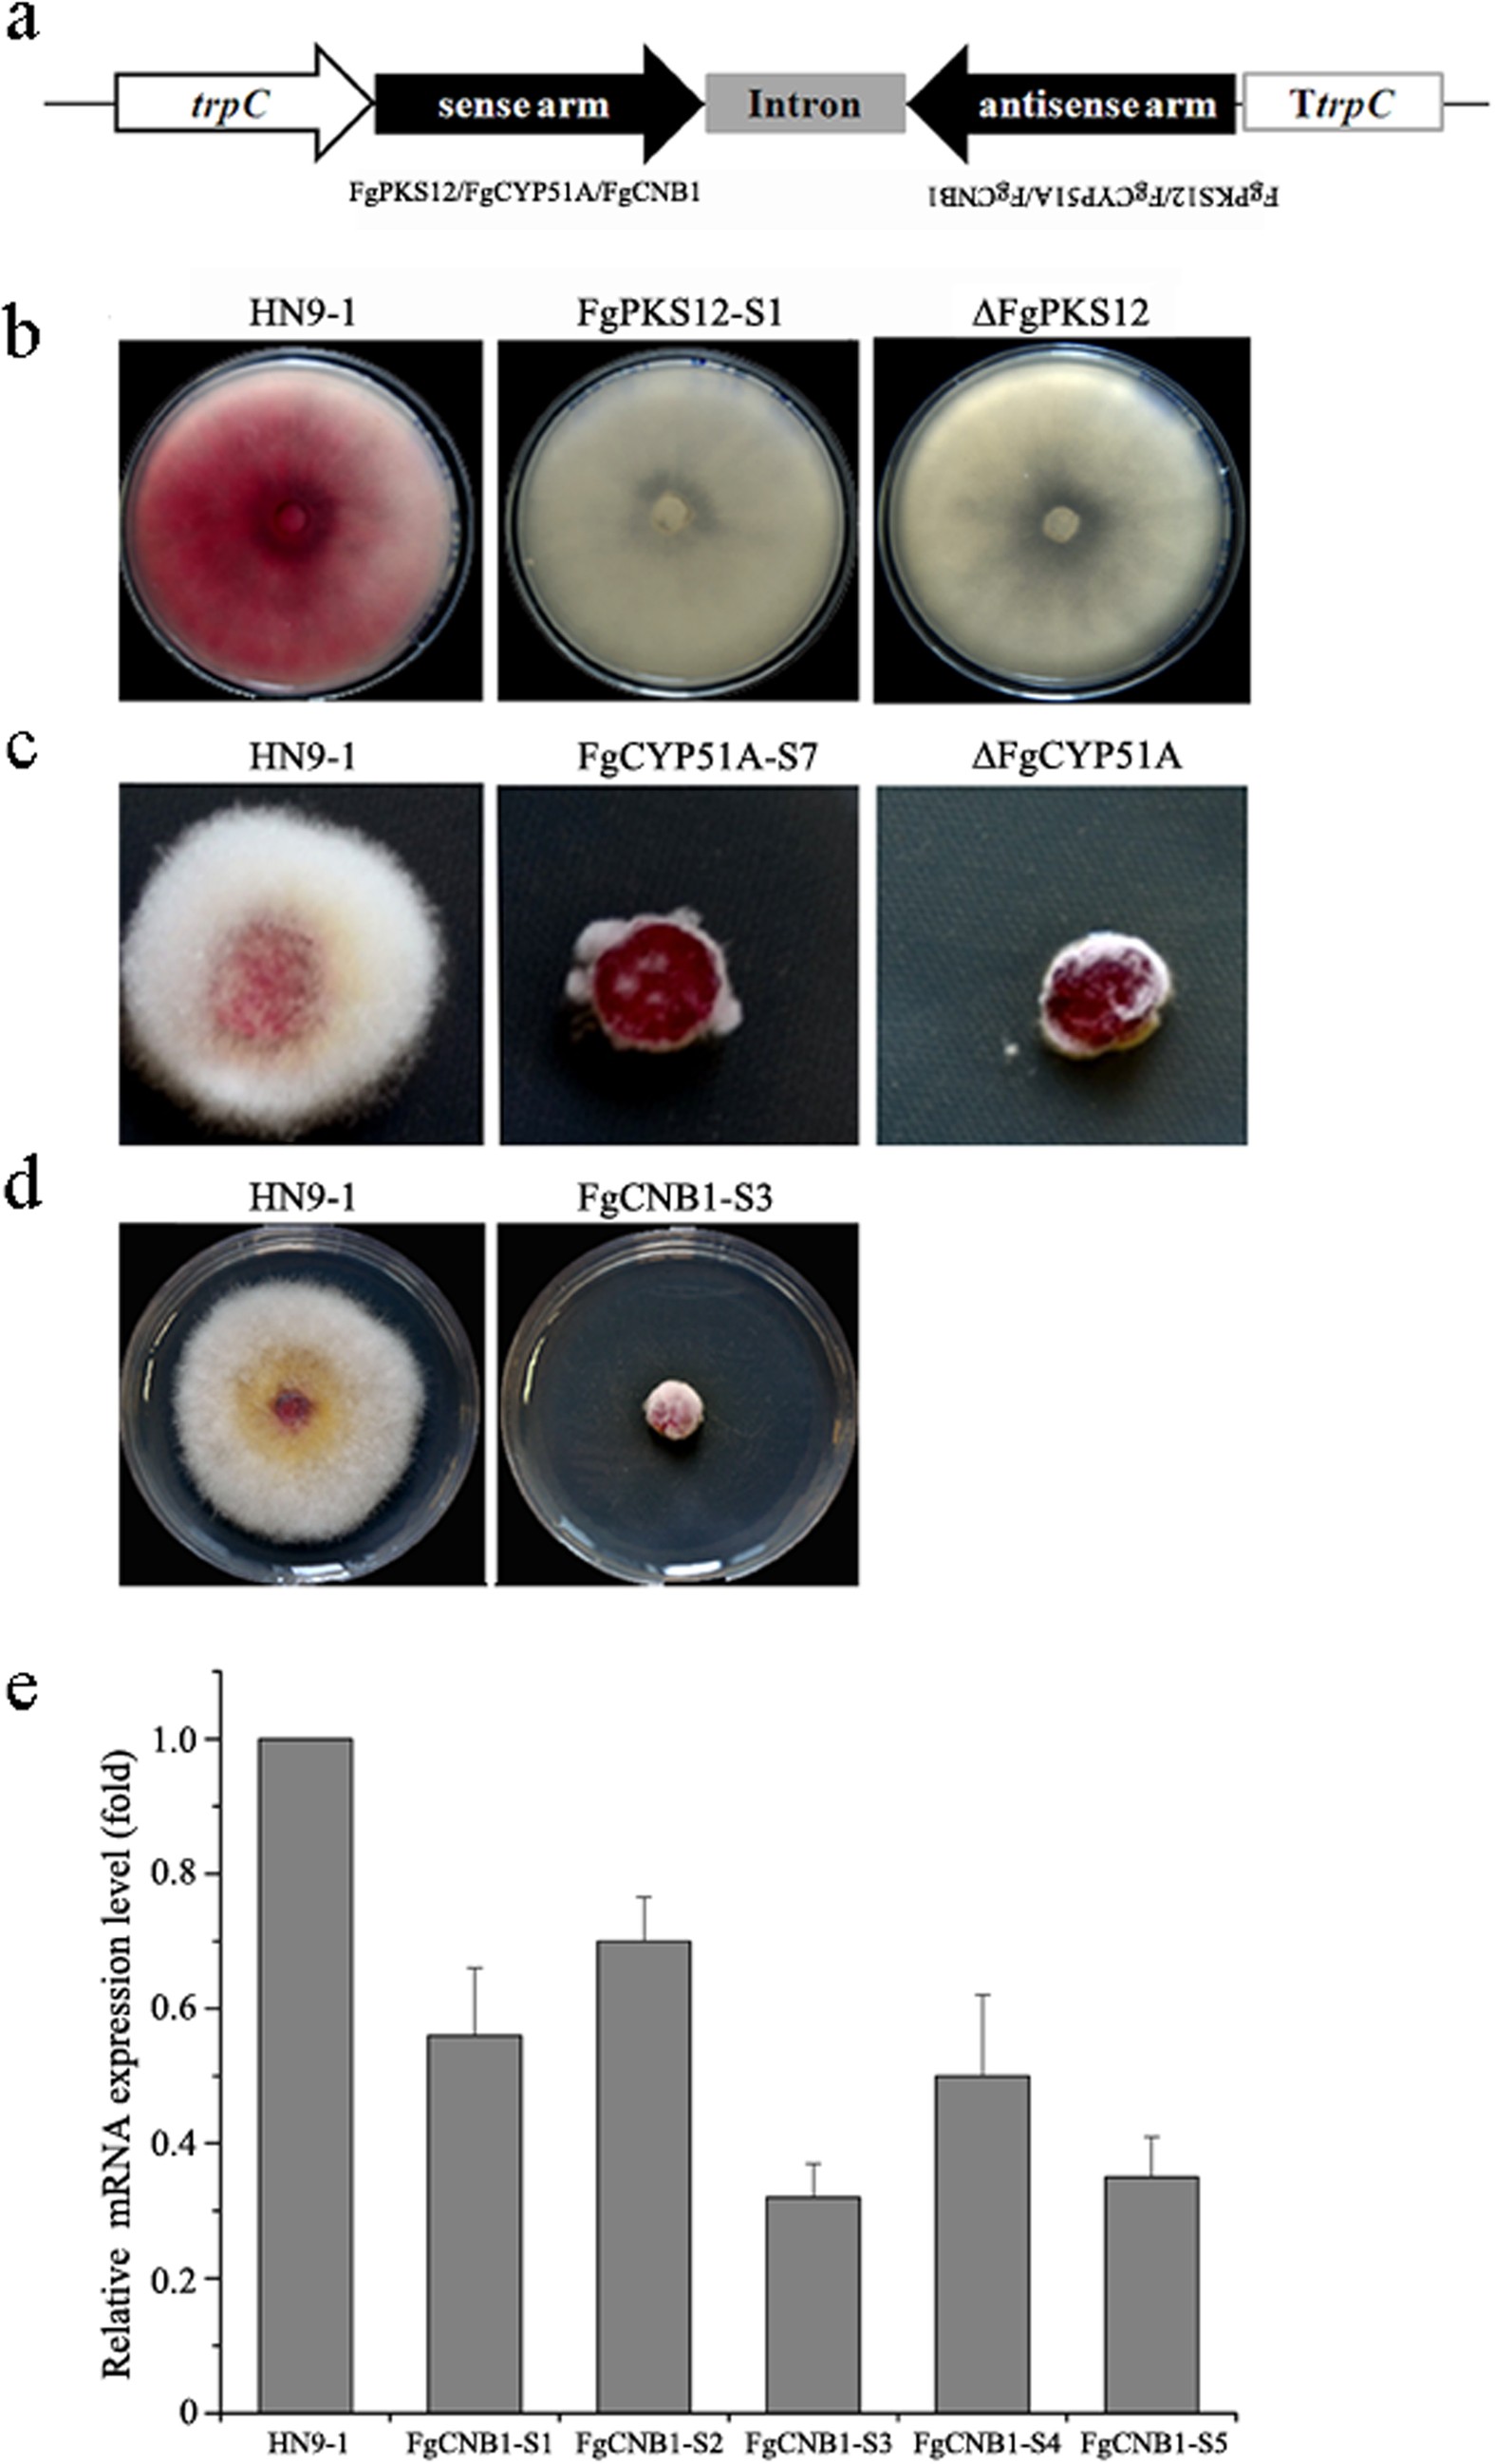
Figure 1

Figure 1
From: Characterization of RNA silencing components in the plant pathogenic fungus Fusarium graminearum
Phenotypic analyses of hpRNA-induced single gene silencing in F. graminearum.
(a) Schematic representation of hpRNA-expressing constructs. The hairpin inverted-repeat targeted region of FgPKS12, FgCYP51A, or FgCNB1 was obtained by PCR and inserted into the multiple cloning site of hpRNA-induced gene silencing vector pSilent-1(b) Colony morphology of the RNAi-silenced FgPKS12 transformant. The wild-type HN9-1 and FgPKS12 gene silencing transformant were grown on PDA for 7 days at 25 °C. The silencing mutant FgPKS12-S1 displayed white colony, similar to the FgPKS12 deletion mutant (∆FgPKS12). (c) Susceptibility of FgCYP51A silencing transformant to the DMI fungicide triadimefon. FgCYP51A silencing transformant FgCYP51A-S7 were grown on PDA supplemented with triadimefon (5 μg mL−1) for 3 days at 25 °C. Similar to the FgCYP51A deletion mutant (∆FgCYP51A), the silencing transformant showed increased sensitivity to triadimefon. (d) Growth pattern of the essential gene FgCNB1 silencing transformant. The FgCNB1 silencing transformant FgCNB1-S3 and the wild-type HN9-1 were cultured on PDA at 25 °C. The image was taken after 3 days of incubation. (e) The relative mRNA expression level of FgCNB1 in silencing transformants in comparison to that in the wild type. Line bars denote standard errors of three repeated experiments.